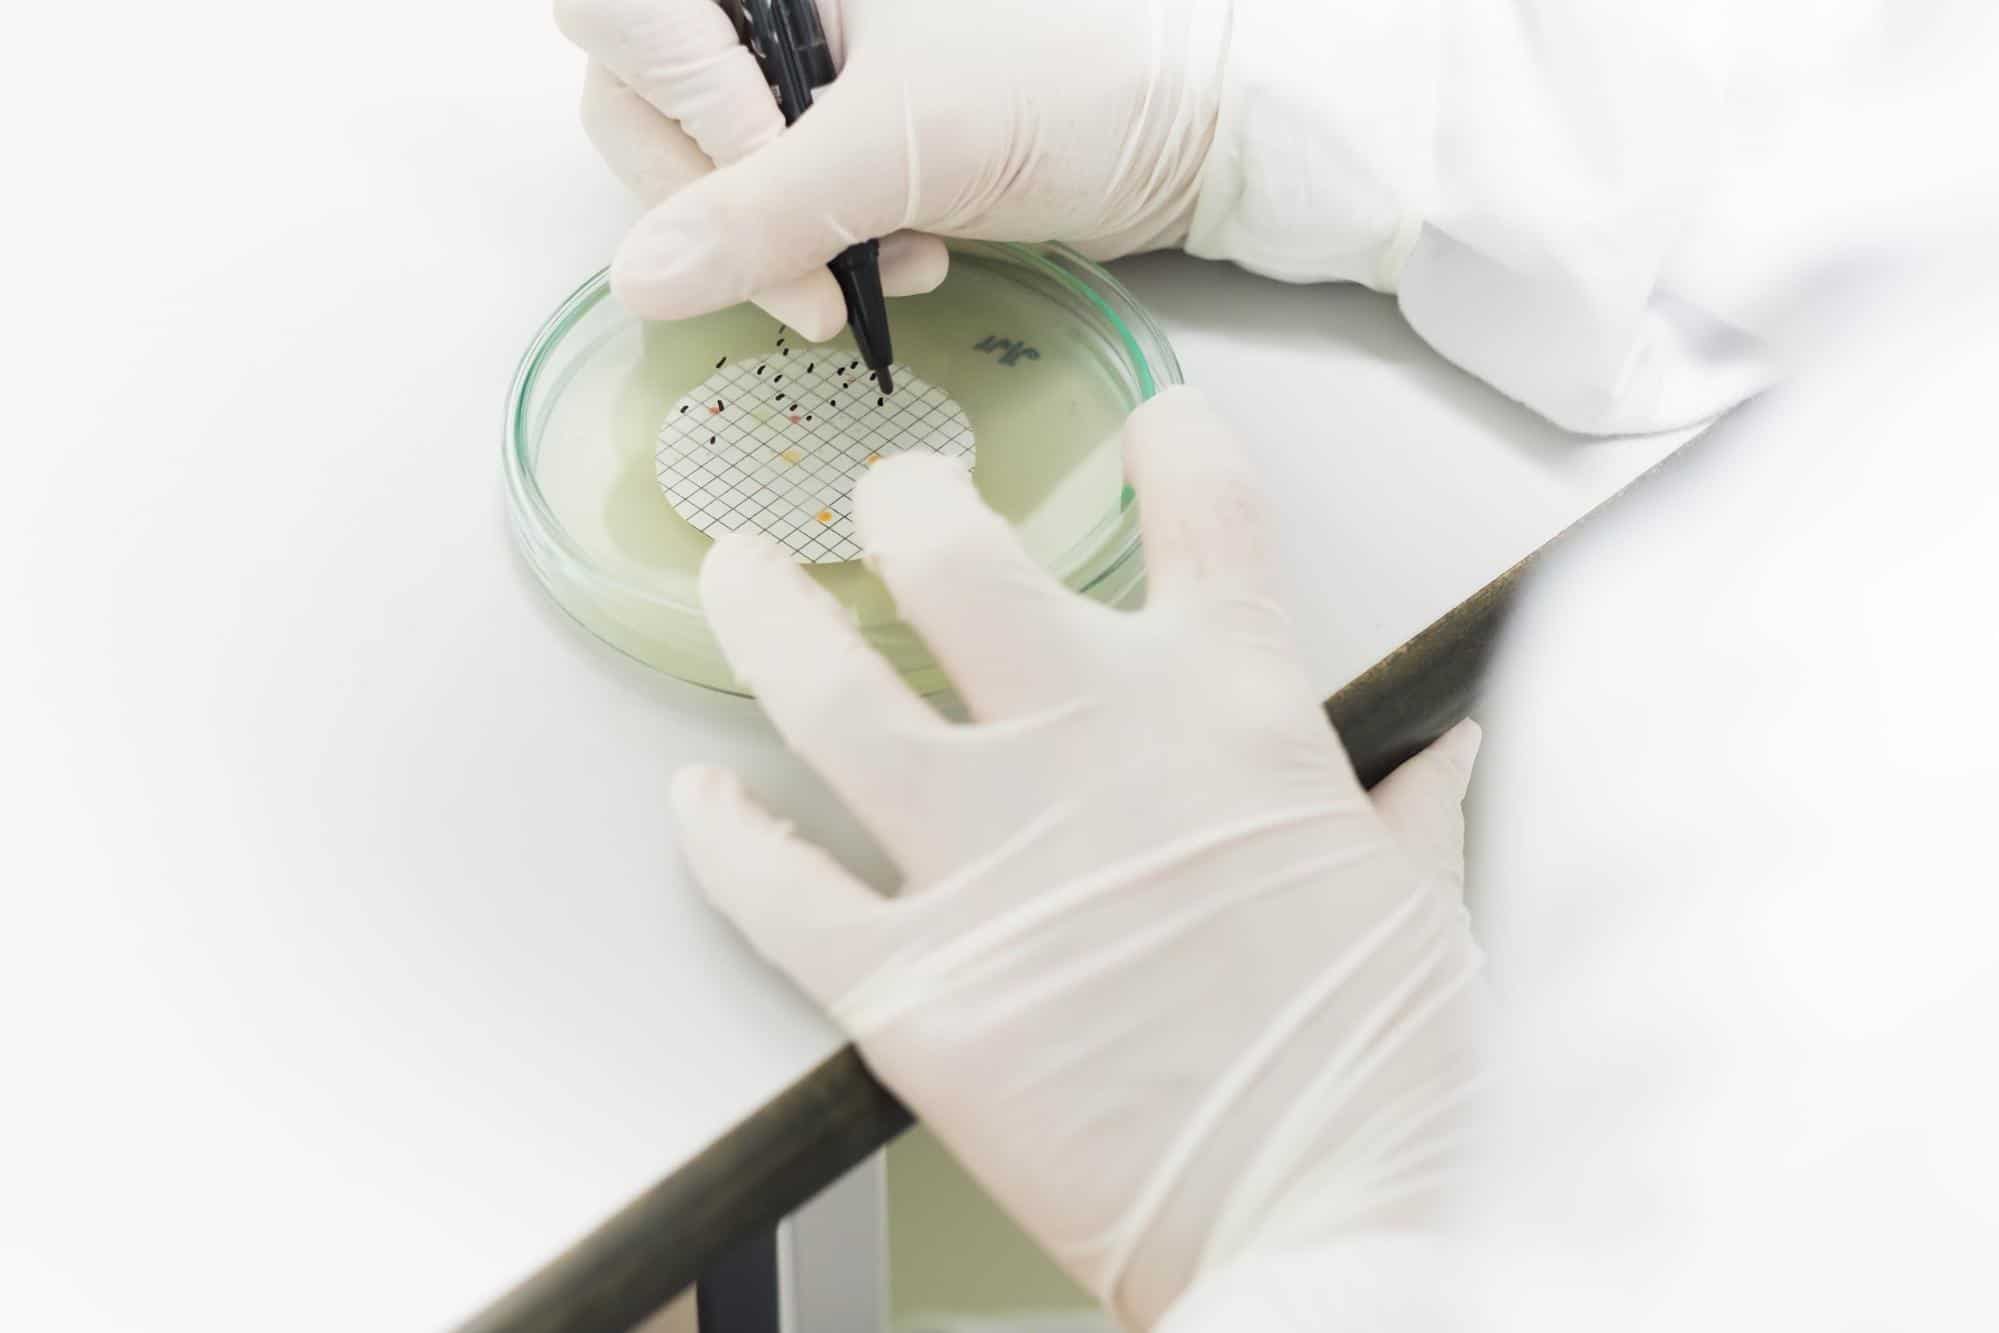

Colony forming units, or CFUs, are a unit of measurement used to determine the number of bacterial cells in a probiotic supplement or lab sample. High CFU counts are sometimes seen as a quality indicator, but it is one part of a high-quality supplement. Bacterial strain combination, the delivery mechanism, and clinical studies should also be taken into consideration,
Many probiotics advertise their high colony forming units (CFUs) as if this is the only marker for quality. Oftentimes, the higher the CFUs, the higher the price. But how are you supposed to know if that really is the mark for quality? Is it worth paying the price for more CFUs, and is it really all that matters?
For many people, checking the number of colony forming units has become common practice when choosing a probiotic. Some companies heavily advertise their superior count. Oftentimes, the higher the CFUs per serving, the higher the price because the belief is that the higher the CFU count, the better. This is NOT correct!
Potency isn’t just a number. When choosing a probiotic supplement, there’s more to consider than just the number of CFUs per serving.
In this blog post, we’ll investigate why CFUs are not all that matters, why higher CFUs doesn’t mean it’s a superior product, and what else to look for that determines a high-quality probiotic supplement.
What Are CFUs?
CFU stands for Colony Forming Units. What this means is the number of alive and active microorganisms in one serving of a probiotic dietary supplement. These are typically measured in CFUs per gram or per milliliter.
A colony refers to the individual colonies of bacteria, yeast or mold growing together. Bacteria, yeasts and viruses are all considered microorganisms.
Probiotic supplements generally consist of good “probiotic” bacteria, and occasionally of yeasts.
When you look at a shelf of probiotic supplements at the grocery store or pharmacy, you will see a wide range of CFUs listed on the supplement facts label.
The average CFU count in probiotics is between 1 and 10 Billion CFUs per serving. Some companies even advertise extremely high counts such as over 100 Billion CFUs.
How Colony Forming Units are Measured and Cultivated
In microbiology, a colony forming unit is used to estimate the number of viable cells of bacteria or fungi in a sample. It’s easier than counting the number of cells themselves. Individual cells are very small and some may be dead whereas others are alive.
To measure the number of colony forming units, a bacterial culture of the microorganism is added to an agar plate (a petri dish with agar solution as a growth medium for the microorganism) in a microbiology laboratory.
Often, this requires serial dilutions of the original sample, as the original sample might be very concentrated.
It’s important to keep track of the number of times the sample was diluted, also called the dilution factor. If the sample is too concentrated, you will see a large area of bacteria, instead of the individual colonies.
After a few days of tracking the bacterial growth, the colonies can be seen as a cluster of bacteria or fungi growing together. These colonies are counted. Then you use a specific formula to calculate CFU.
A single colony often has a circular pattern. The reason why CFUs matter especially for probiotics is because they indicate how many living beneficial bacterial cells you ingest with your probiotic.
In order for the probiotic to be effective, the good bacteria you swallow should be alive. Otherwise you’re just flushing money down the toilet, literally!
How Many Bacterial Colonies Do You Need In a Probiotic?
The average probiotic supplement has between 1 billion and 10 billion CFUs per serving.
In recent years, some companies have focused on extremely high CFU counts, claiming that higher CFUs means better results.
But don’t be fooled—higher CFUs doesn’t necessarily mean it’s a better product.
Potency is More than Just a Number
The number of bacteria isn’t all that matters when choosing a high-quality probiotic.
The gut contains 400 to 600 different bacterial strains and species. The goal with taking a probiotic supplement is to add beneficial bacteria back into the gut so that these bacteria can improve the overall environment in the gut.
Of course, you want to take a high enough quantity of bacteria to ensure that these can make a positive difference in the gut.
At the same time, taking too high an amount of one or a few specific strains of bacteria may actually have a negative effect.
You might experience digestive upset, or the bacteria will flush through you without having an impact and leave your body when you use the bathroom.
If a High CFU Count is Not a Quality Indicator, What is?
Considering that the number of CFUs isn’t a great indicator for probiotic quality, here’s what you should focus on instead when it comes to determining the quality of a probiotic:
The Combination of Bacterial Strains
Each one of the 400 to 600 probiotic bacterial strains in your gut carry out a different function.
That’s why you, first and foremost, want to opt for a multispecies and multistrain probiotic supplement. Furthermore, you want to make sure that the probiotic includes the right kind of probiotic bacterial strains that address your health needs.
For example, you should take a different combination of bacterial strains for when you have a bad case of traveler’s diarrhea compared to when you’re dealing with leaky gut.
At OMNi-BiOTiC®, we apply years of scientific research and deep knowledge for what each specific bacterial strain does to the development of our probiotics. This allows us to combine specific bacterial strains that work hand in hand to address different health goals.
Clinical Studies and Scientific Evidence
Developing a multispecies/multistrain probiotic is not as simple as to just combine bacterial strains that are commonly known to have a positive impact. You have to know which bacterial strains work well together, rather than competing with each other.
In a groundbreaking study, scientists examined the gut microbiome of identical twins. They concluded that our gut bacteria play a critical role in the metabolic processes in the body, and that there is an “intense interplay” between our gut bacteria and our body.
They also found that certain gut bacteria work best in teams to perform specific functions. These findings emphasize the approach taken at OMNi-BiOTiC®, where our products are carefully combined multispecies probiotic supplements with a significant understanding for the tasks performed by each strain.
At OMNi-BiOTiC®, we have researched bacterial strains for 25 years. Our researchers understand what each strain we use in our products does, how they work together and how much of each strain is needed for optimal results.
In addition, the final probiotic combination is tested for efficacy, first in the laboratory and then in clinical studies with people.
This deep scientific research and testing is, unfortunately, not the norm for probiotics. However, it is very important and immensely influences the efficacy and safety of a product

The Delivery Mechanism
Another important factor is the delivery mechanism, meaning how the product is manufactured and ingested.
In order for you to truly see the benefits of probiotics, the bacterial species have to survive the journey from the manufacturer to the store, to your house and eventually through your gastro-intestinal tract into your large intestine.
This can pose many challenges, including changes in temperature and moisture, and exposure to the acid in your stomach.
Unfortunately, in many probiotic supplements, a majority of the good bacteria die before you even get the chance to ingest them. And even if the bacteria survive and make it into your mouth, probiotics in capsules and chewables often don’t survive the passage through the acidic environment of the stomach.
In this case, what use is a high CFU count to you, if the vast majority of the bacteria die before they even reach the large intestine where they can get to work?
At OMNi-BiOTiC®, we manufacture our probiotics in a powder form. The bacteria are freeze-dried and held in sophisticated sachets, which protects the microorganisms throughout transport.
You then have to dissolve the probiotic powder in water to activate the beneficial bacteria and make them strong for their passage through the stomach into your intestines. 90% of the beneficial bacteria survive and can perform their important tasks in your gut.
Instead of focusing on CFUs, we urge you to focus on the efficacy, science and delivery mechanism of your probiotic supplement.

How to Tell if the Bacterial Colonies in Probiotics are Working
Many people immediately think of better digestion when they hear probiotics. It’s true, beneficial bacteria in the gut play a very important role in proper digestion.
Improvements in digestion is often one of the first benefits people notice when taking probiotics. This may be more regular bowel movements, less bloating or gas, fewer cravings and less fatigue after meals.
The good bacteria in the gut support many other important processes in the body. These include: nutrient absorption, boosting the immune system, and even improved cognitive function, mood, and sleep.
Furthermore, scientists have investigated the connection between the gut and different diseases. They have already discovered a connection between an imbalance in our gut bacteria and illnesses including anxiety, depression, Alzheimer’s Disease and migraines.
Depending on your overall health, you may notice some of the following positive effects when taking a high-quality probiotic, which will also signal that your probiotics are working. For more information on how to tell if your probiotics are working, check out our blog post on this topic.
Improved Digestion and More Regular Bowel Movements
Whether you’re suffering from constipation, diarrhea and/or gas, the bacterial cell colonies in a high-quality probiotic can help to balance your gut bacteria, fight the growth of potentially harmful bacteria (such as E. coli or Clostridium difficile), yeasts, and viruses, and with that optimize digestion and bowel movements.
Increased Energy
Your body gets its energy from the nutrients and micronutrients in your food. The gut plays a critical role in absorbing these nutrients. If your gut bacteria are out of balance or your gut is inflamed, nutrients are not taken up as efficiently. This can affect your energy levels.
A Strong Immune System
A large portion of the immune system lies in the gut, and our probiotic bacteria play an important role in maintaining strong immune function.
Certain bacterial strains have the ability to activate the immune system or to change the PH in the intestines to make the environment less pleasant for harmful viruses.
In addition, the gut plays a critical role in absorbing all essential nutrients from the food you ingest. Many of these nutrients are important for immune function, including your B vitamins, Zinc and Vitamin C. If the gut wall is inflamed due to an imbalance in gut bacteria, fewer nutrients get into the body. Over time, this can take a toll on the immune system.
Lower Anxiety and Improved Mood
The gut and the brain stand in close communication with one another. Some even call the gut the “second brain.” Often, negative mood and depression are correlated to a change in the gut microbiome.
Our gut bacteria actually produce some of the neurotransmitters that then travel to the brain and influence our mood. An imbalance in gut bacteria (dysbiosis) has been associated with depression and anxiety.
Better Response to Stress
Stress can kill the good bacteria in the gut. Replenishing our gut with beneficial bacteria during times of stress can help support digestion, strengthen the immune system, and even improve cognition and mood.
Weight Loss
There’s growing evidence that the composition of the gut microbiome is linked to a person’s metabolism and body weight. Certain probiotic supplements that contain the right combination of bacterial strains can help rebalance the composition of bacteria in the gut and help with weight loss.
Another common problem is that certain bacteria and yeasts (such as Candida) can trick the body into craving sugar, which also leads to weight gain.
A high-quality probiotic can help rebalance the diversity of good bacteria in your gut, which in turn can affect your metabolism and what types of foods you crave.
Improved Cognitive Function and Memory
The gut and the brain stand in direct communication, and our gut bacteria produce important messenger signals and substances for the brain. If the gut flora is out of balance, this can affect these processes.
In a clinical study, healthy participants took OMNi-BiOTiC® STRESS Release for 4 weeks. They reported improvements in mood, memory, focus and concentration.
Fewer Sugar Cravings
Intense sugar cravings can be a sign of bacterial overgrowth in your gut. Certain bacteria as well as yeasts can trick the brain into craving lots of sugar, as sugar is their favorite food to help them reproduce as quickly as possible.
One example is the common yeast Candida Albicans. Overgrowth of Candida in the gut can be felt as bloating and flatulence, strong sugar cravings and a thick white coating on your tongue.
Probiotics can help rebalance your gut bacteria, reduce the amount of pathogens such as Candida, and therefore help reduce your sugar cravings.

How to Choose the Right Probiotic for You
Not all probiotics are safe and effective. Consumers have been trained to focus on criteria, like CFUs, that actually don’t determine a probiotics’ impactfulness.
What matters most is the selection and combination of probiotic strains, and the delivery mechanism. These factors are what matter far more than an unnecessarily high colony or cell count.
For best results, pick a probiotic that is rooted in scientific research and clinical studies, as well as mindfully formulated to address your health needs. If you’re suffering from occasional constipation, you likely will need a different probiotic than if you’re experiencing frequent urinary tract infections or are struggling with anxiety.
At OMNi-BiOTiC®, each probiotic is extensively studied and tested prior to market introduction, from early development including strain analysis, to clinical trials and an innovative powder formulation that ensures high effectiveness. Our products only include highly active bacteria and are delivered in our unique powder formulation that ensures a much higher delivery of living bacteria into the intestines.
In essence, the colony forming units are successfully delivered in their viable forms into the intestines.
To learn more you can take our product fit quiz and discover the best probiotic for your health goals.
FAQ’S:
1. What does CFU stand for in probiotics?
CFU stands for Colony Forming Unit. It measures the number of viable microorganisms in a probiotic supplement, indicating its potency and potential effectiveness in promoting gut health.
2. How are CFUs measured in probiotics?
CFUs are determined by culturing a sample of the probiotic on an agar plate and counting the number of colonies that form. Each colony originates from a single viable microorganism, providing an estimate of the number of live organisms present.
3. Why are CFUs important in probiotic supplements?
CFUs indicate the number of live microorganisms in a probiotic supplement, which is crucial for its effectiveness. A higher CFU count suggests a greater number of beneficial bacteria, potentially offering more significant health benefits.
4. Does a higher CFU count always mean a better probiotic?
Not necessarily. While a higher CFU count indicates more live microorganisms, the quality of the probiotic also depends on factors like strain diversity, delivery method, and individual health needs.
5. What is the average CFU count in probiotic supplements?
Answer: Most probiotic supplements contain between 1 and 10 billion CFUs per serving. However, some products may advertise counts exceeding 100 billion CFUs.
6. How do CFUs relate to gut health?
CFUs represent the number of live beneficial microorganisms that can colonize the gut, supporting a balanced microbiome, enhancing digestion, and promoting overall gut health.
7. Can CFU count be misleading in probiotic supplements?
Yes, focusing solely on CFU count can be misleading. It's essential to consider the specific strains used, their clinical efficacy, and how well the supplement delivers these microorganisms to the gut.
8. Are there probiotics with CFU counts over 100 billion?
Yes, some probiotic supplements advertise CFU counts exceeding 100 billion. However, higher CFU counts do not always correlate with better health outcomes and should be considered alongside other factors.
9. How can I determine the right CFU count for my needs?
Consulting with a healthcare professional can help determine the appropriate CFU count based on individual health goals, existing gut health, and specific probiotic strains.
10. Do CFU counts change over time in probiotic supplements?
Yes, CFU counts can decrease over time due to factors like storage conditions and product age. It's important to choose supplements that guarantee potency through the expiration date.